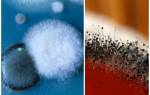

Причины появления плесени в бане
Во влажном помещении могут появиться два вида плесени: белая и черная. Черная плесень порождает древесину очень быстро и, без скорейшего вмешательства может привести к замене всего внутреннего покрытия, а в худшем случае и к поражению несущих опор здания. Белая плесень выделяет невероятно токсичные споры, способные навредить здоровью и вызвать ряд хронических заболеваний.
Плесень на вагоне в бане может образовываться из-за:
- Использования зараженной грибком древесины.
- Несоблюдение послойности в устройстве паро и гидроизоляции в бане.
- Нарушений в системе вентиляции.
- Промерзания конструкции и не регулярное протапливание бани в холодный период.
Причины появления плесени в бане
Пытаться просто вывести плесень без устранения причин ее возникновения – бессмысленно. Разбираться нужно с причинами, а не со следствием.
Основные причины:
- Отсутствие нормальной вентиляционной системы или ее плохая работоспособность. В герметичном помещении повышенная влажность может поддерживаться постоянно, даже если вы откроете дверь после посещения бани: воздух попросту не будет нормально циркулировать. Такое бывает, если вентиляцию не делают вообще, или делают неправильно, или делают, но со временем она забивается или повреждается.
- Отсутствие окон, и как следствие, отсутствие солнечного света (плесень хорошо себя чувствует в помещениях, где мало ультрафиолета).
- Чрезмерная постоянная влажность – один из основных факторов развития плесневой инвазии.
- Каркас бани сделан из древесины, либо же из древесины сделана ее внутренняя отделка. Споры обожают деревянные поверхности, быстро разрастаясь на них. А выводить грибок с дерева сложнее всего. Нередко бывает такое, что плесень настолько въедается в древесину, что отделку приходится только заменять.
- Отсутствие или неправильно выполненное утепление, или утепление только изнутри. Если утепления нет вообще, или оно недостаточно толстое, на внутренней поверхности зимой будет скапливаться конденсат (а во влажных условиях конденсата будет очень много). Если утепление выполнено только изнутри, может сместиться точка росы, и конденсат будет появляться между утеплителем и деревом (то есть из комнаты его видно не будет).
- Отсутствие наружной гидроизоляции.
В чем опасность?
Если баня или ее внутренняя отделка сделана из древесины – появление плесени приведет к катастрофе. Начнут гнить пораженные деревянные конструкции, причем очень быстро. Они могут стать непригодными для эксплуатации уже через 2-3 года с момента заражения.
Серьезной проблемой является влияние плесени на людей, которые будут посещать парилку. Плесневые споры приводят к развитию целого ряда аллергических заболеваний, включая бронхиальную астму.
Также они могут привести к аутоиммунным заболеваниям, включая болезни с поражением сосудов и сердца. Возможен перенос заражения – споры могут попадать на одежду посетителей и заноситься в их дома.
Где именно чаще всего появляется плесень?
Чаще всего плесень появляется в самой парилке, потому что там постоянно тепло и влажно (для грибка просто идеальные условия). Но нередко очаги появляются и в других местах, включая предбанник и комнату отдыха. Происходит такое, когда в этих помещениях отсутствует или плохо работает вентиляция, и они не проветриваются после банных процедур. Причина заключается в воде, которую посетители оставляют в предбаннике и комнате для отдыха. Если не проветривать эти помещения, внутри них повысится влажность.
Больше всего подвержены заражению деревянные постройки, либо помещения с деревянной отделкой изнутри. Искать грибок нужно в первую очередь по углам и на стенах, в особенности по углам примыкания стен.
Несколько реже очаги локализуются на полу, а еще реже они бывают на потолке, обычно уже после поражения других участков.
Избавление в процессе эксплуатации
Если помещение постоянно не отапливается, это является благоприятной средой для образования грибка. Наибольшее значение необходимо уделять постройкам из дерева, поскольку они находятся в основной группе риска.
Плесень может появиться на любой поверхности в помещении с повышенной влажностью. Грибок размножается на полу, потолке или стенах, а также в углах. Если парилка плохо утеплена, плесень образуется там очень скоро. При обнаружении первых симптомов грибка необходимо немедленно приступать к его выведению. Есть три известных способа, как избавиться от грибка в бане:
- Народными средствами.
- Механическим. Зачистка поверхности щёткой или шлифовальной машинкой.
- Магазинными препаратами.
Под народными способами или магазинными средствами подразумевают обработку заражённого материала агрессивными веществами.
В бане грибком чаще заражён пол. В этом случае желательно доски с плесенью убрать, удалить часть почвы. Она тоже может оказаться заражённой. Доски с грибком срочно заменить. Остальные обработать антисептическими средствами.
Чтобы избежать аналогичных проблем в будущем, баню нужно ежедневно протапливать, а после использования по назначению хорошо проветривать. Если появилась плесень в бане, нужно обязательно знать, как избавиться от нее. Можно воспользоваться средством из магазина, предназначенным для уничтожения грибка.
Проверка и обработка вентиляции
До начала обработки потолка, стен, углов и пола необходимо тщательно просмотреть вентиляционную систему. Первым делом открыть затворки и обследовать вентиляционный канал. Некоторые владельцы бань и саун источник появления плесени эффективно устраняют благодаря установке вентилятора возле решёток.
Саму систему вентиляции можно обработать специальной грунтовкой. Необходимо выбирать препарат, предназначенный для работы с деревянными поверхностями
Но при этом придерживаться дозировки и соблюдать меры предосторожности, чтобы не обжечь кожу
Антисептические средства
Специальные профессиональные препараты помогут избавиться от грибка быстро и надолго. Желательно остановить выбор на товарах известных производителей, таких как Биотоп, Церезит, Метас-Био, Дали, Неомид-Био. При покупке химии неизвестных фирм эффекта может не быть, а деньги будут потрачены.
Стоимость средств различная в зависимости от фирмы-производителя. Применять особые химические составы нужно осмотрительно. Некоторые сильно впитываются в древесину, а затем в процессе нагревания потолка, пола и стен начинают выделять в воздух токсины, вредные для здоровья. Необходимо покупать готовый состав глубокого проникновения, предназначенный именно для обработки потолка, пола и стен бань и саун.
Механическая зачистка
Если грибок проник не очень глубоко, можно попробовать зачистить поражённую поверхность. Работа не очень сложная.
Для этого понадобятся:
- Наждак.
- Шпатель.
- Шлифовальная машинка.
- Щётка по металлу.
После удаления плесени механическим способом отходы лучше всего сжечь. Благодаря этому будет предотвращено развитие плесени на остальных объектах. Механическую очистку используют при глубоком проникновении грибка. Часть бревна выпиливают и туда вставляют новый материал.
Народные способы
Грибок в бане можно уничтожить народными способами. Они эффективны и не затрачивают много времени.
Для борьбы с плесенью применяют:
- Хлорную известь, состоящую из воды и негашеной извёстки. Раствор наносится на подготовленную сухую поверхность.
- Медный купорос, который можно приобрести в магазинах для садоводов. Чтобы получить раствор, надо на 1 литр воды взять 50 грамм купороса, 30 грамм поваренной соли и 100 грамм алюмокалиевых квасцов. До обработки стен средством нужно поверхность просушить, сделать раствор согласно инструкции, нанести его на стены кисточкой. Процедуру через две недели повторить.
- Серу. Этот метод дешёвый и эффективный. В тазике или ведре необходимо поджечь серную шашку. При горении она выделяет газы, эффективно устраняя споры грибка.
- Перекись водорода 25%. Нужно её аккуратно нанести на древесину и оставить. Через несколько часов поверхность протереть влажной тряпкой.
- Белизну. Ее продают в любом магазине по недорогой цене. Нанести средство на стены, затем их обработать водой.
- Можно покрыть поверхности брёвен уксусной кислотой 70%. Но это решает проблему только временно. Надо отремонтировать систему вентиляции.
Чем обработать баню от плесени
Существует много средств, которые помогают уничтожить плесень. Их можно как приобрести в магазине в виде готового раствора, так и сделать самостоятельно. Антисептики для поверхностного и глубокого применения лучше покупать известных и проверенных брендов, которые гарантируют защиту досок и положительный результат по устранению плесени. Это, например:
- Биотол;
- Метас-Био;
- Церезит;
- Дали;
- Неомид-Био;
- Эрлин;
- Пентатос.
Из народных средств, чем можно вывести грибок в бане, выбирают:
- Хлорную известь, которая состоит из негашеной хлорной известки и простой воды. Ее наносят на сухую поверхность.
- Медный купорос: он продается повсеместно в магазинах, которые специализируются на садоводстве. Если делать раствор на литр воды, то нужно взять пятьдесят грамм купороса, сто грамм алюмокалиевых квасцов и тридцать грамм поваренной соли.
- Серу, цена на которую низкая, а результат – быстрый и идеальный. В огнеупорной емкости (таз, ведро) поджигается серная шашка, которая в процессе сжигания выделяет газ, разрушая споры грибка во всем помещении.
- Перекись водорода в 20-25% наносят на древесину и оставляют на несколько часов, а после протирают смоченной в воде тряпкой.
- Обычную белизну, которую можно купить по доступной цене в хозяйственных магазинах. После нанесения этого вещества следует стены дополнительно обработать водой.
- Что такое ветрянка у детей и взрослых. Первые признаки, симптомы и сроки лечения ветряной оспы
- Применение масла черного тмина: инструкция и отзывы
- Лечение дизентерии у взрослых в домашних условиях. Медикаментозное и народное лечение дизентерии у взрослых
Механическая зачистка поверхности
Если глубина проникновения грибка не очень значительная, то можно воспользоваться механической зачисткой пораженной области. Для этого пригодятся строительные инструменты и приспособления: шпатель, наждак, металлическая щетка, шлифовальная машинка. После того как видимые участки с плесенью будут удалены, отходы желательно сжечь, чтобы предотвратить развитие грибка на других объектах. Механическую очистку используют еще и при глубинном проникновении плесени, выпиливая кусок древесины и вставляя туда новый материал.
Обработка дерева от грибка народными средствами
Чем вывести грибок в бане? Лучше всего помогают народные средства, проверенные не одним поколением. Хлорная известь, медный купорос, серная шашка, перекись водорода и бытовая белизна отлично справляются с грибком, отличаются низкой ценой. При использовании этих составов следует придерживаться инструкции приготовления, а также надевать защитную маску, чтобы в организм не попали пары вредных веществ. В случае с серной шашкой из помещения необходимо выйти, а окна, двери и все щели – плотно закрыть.
Антисептические средства от плесени
Помимо механического избавления от грибка или использования народных средств, рекомендовано приобрести и профессиональные препараты. Отлично справятся с плесенью магазинные антисептики поверхностного и глубинного проникновения, которые совершенно разные по цене. Чем вывести грибок в бане надолго? Выбор лучше остановить на товарах проверенных производителей, как например, Биотол, Метас-Био, Церезит, Дали, Неомид-Био, потому что химия малоизвестных фирм может не помочь, а деньги будут потрачены.
Как избавиться от грибка в бане?
Чтобы уничтожить плесень и не допустить ее повторного появления на бревнах, одна лишь обработка спецсредствами не поможет. Это может временно удалить налет, однако если микроклимат помещения не изменится — грибок появится снова.
Нужно кардинально изменить условия использования помещений и ухода за ними:
- Нельзя допускать, чтобы в помещении была постоянная сырость и влажность.
- Нужно максимально увеличить циркуляцию воздуха. Желательно использовать принудительную вентиляцию (приточные установки, вытяжки) — она позволит максимально быстро обновить воздух.
- В идеале — нужно обеспечить доступ солнечного света в помещение. Пункт не обязательный, куда важнее обеспечить вентиляцию и предотвращать сырость. Однако если в бане будут хотя бы небольшие окошки (для попадания света) — это будет полезно.
Бороться с грибком нужно сразу, как только вы заметили, что на поверхностях появилась черная или белая плесень.
Теперь о том, что делать, если вы заметили плесенный налет в своей бане:
- Если в бане сыро, принесите в нее все вентиляторы и обогреватели, чтобы прогреть, просушить и обеспечить максимальную циркуляцию воздушных масс. Если при постройке система вентиляции была продумана (есть хотя бы приточный клапан в стене, через который воздух будет поступать), задача значительно упрощается.
- Пока помещение проветривается и просушивается, внимательно изучите все внутренние поверхности. Особенно внимательно осматривайте углы пола и потолка, стыки (между досками), участки вокруг окон и дверей, участки, которые прикрыты мебелью, участки, на которые не попадает солнечный свет.
- Если поражение грибком едва заметное, можно сразу обрабатывать поверхность спецсредствами. Если очаги большие, и налет осязаем, его нужно счищать с помощью шпателя и щетки по металлу. Если же плесень въелась в отделочные материалы, лучше всего их демонтировать: даже после обработки споры могут остаться внутри.
- Теперь выбираем средство (из приведенного ниже списка) и наносим его на зачищенные участки. Обрабатывать нужно не только пораженную зону — захватывайте как минимум по 30-50 сантиметров вокруг нее.
- Даем средству сработать (сколько времени надо — зависит от того, чем именно вы делали обработку).
- Затем счищаем еще раз налет с помощью металлической щетки, хорошо вымываем участки и еще раз просушиваем все помещение.
При сильном поражении действия из пунктов 4 и 5 нужно провести повторно.
Чем обработать плесень в бане: список средств
Вывести грибок – задача хоть и трудоемкая, но выполнимая. В этом могут помочь как народные, так и современные методы.
Эффективными препаратами для уничтожения колоний плесенных грибов являются:
- уксус от плесени;
- медный купорос;
- белизна от плесени;
- хлорная известь;
- сера;
- перекись водорода от плесени.
Если вы предпочитаете более современные средства, или если площадь поражения очень большая – идите в хозяйственный магазин. Там вы сможете выбрать средство поверхностного или глубокого воздействия, предназначенное специально для удаления плесени.
Список средств, которые можно применять:
- Сенежа;
- Вiotol;
- Dufa (в основе — хлор);
- Ceresit;
- Метас-Био;
- Neomid-Bio;
- ALFA-Фонгифлюид;
- Олимп-Стоп.
Можно выбирать и другие спецсредства — выше приведены далеко не все названия.
Устраняем причины появления плесени в бане: профилактика
Борьба с грибком заключается не только в разовом уничтожении очага заражения. Профилактика появления грибка — не менее важный этап.
Грибок в углу на стыках бревен
Для устранения причин появления плесени необходимо:
- Обеспечить полноценную вентиляцию в бане. Для этого нужно установить приточный стеновой клапан или оконный клапан в каждой комнате. Он позволит не терять герметичность во время пребывания в бане, при этом можно будет качественно проветривать ее после каждого посещения.
- По возможности в парилке стоит сделать хотя бы небольшое окошко. В этом случае не обязательно будет ставить для нее приточный клапан.
- Периодически обрабатывать антисептиком, желательно в несколько слоев, места, в которых грибок развивается активнее всего. Если плесень до этого нигде не появлялась, то для профилактики можете обрабатывать углы и стыки.
- Регулярно проветривать баню. После каждого посещения все комнаты, включая парилку, должны быть провентилированы и высушены досуха. Оставляйте открытыми настежь двери и окна, если есть — включайте вытяжные и приточные устройства.
- Внешнее утепление стен и гидроизоляция также помогут в борьбе со злостным вредителем. Делать это можно как на этапе строительства, так и если здание уже построено.
Выполняя все правила содержания и ухода за баней, можно будет предотвратить появление плесени.
Промышленные средства для борьбы с грибком
Можно прибегнуть к помощи специалистов, которые борются с заражением профессиональными инструментами и средствами, или же выполнить эту работу самостоятельно. Если вы решили справиться с проблемой своими руками, то сперва нужно найти причину появления плесени и устранить ее. Проверьте качество гидроизоляции, вентиляции, уклон стока. То есть обеспечьте помещению просушку, иначе повторное появление колонии – вопрос времени. Влажный воздух не должен стоять в бане.
Следующим шагом будет осмотр пораженных участков. Если грибок ушел глубоко в дерево, необходимо удалить почерневший элемент. В идеале – целиком, но если это невозможно, но нужно будет выпилить сегмент, захватив и здоровые участки. Удаленные части лучше сжигать сразу же, чтобы не допустить распространения спор.
Перед тем как приступить к зачистке, наденьте маску, перчатки и одежду, с которой готовы будете расстаться. Дело в том, что споры очень легко распространяются в воздухе и оседают на новые чистые участки. Ткань одежды также является их излюбленным местом обитания, некоторые виды плесени устойчивы даже к стирке и глажке. Обработайте черное пятно небольшим количеством воды, чтобы не допустить «взлета» спор. Не подпускайте к зараженному участку животных и детей.
Что необходимо сделать для удаления плесени со стен
| Этапы обработки | Каким образом это делается |
| Первый: механическая очистка от грибка. | Выполняется она с помощью шпателя, грубой щетки или шлифовальной машинки. Постарайтесь дочиста удалить гниющие материалы, двигайтесь вглубь. Полученную стружку и опилки сожгите. |
| Второй: обработка антисептиком глубокого проникновения. | У каждого продукта свой способ применения, который описывается в инструкции. Общая рекомендация одна: покрывайте им не только зачищенный участок, но и прилегающие, ведь вы могли не заметить молодую колонию, или туда могли попасть споры во время механической очистки. |
Производители химических средств предлагают большой ряд товаров для использования в деревянных банях в качестве антисептика. Наиболее популярные: Biotol, DUFA, Dali, «ОЛИМП-Стоп», «Сенежа». Эти растворы предназначены специально для обработки деревянных конструкций в помещениях, где находятся люди.
Приобретайте только те товары, которые предназначены для жилых помещений, т. к. они разрабатываются с соблюдением условий экологичности и безопасности. Вещества, разработанные для применения на промышленных предприятиях и на складах, не подойдут.
Не покупайте средства в местах, не вызывающих доверия. Мало того что они могут оказаться неэффективными. Всегда существует вероятность отравления с непредсказуемым исходом.
Опасность для человека
Все виды плесени представляют опасность для человека. Продуктами их обмена веществ являются сильные яды, вызывающие отравление. Споры плесени несут серьезный риск респираторных заболеваний. В помещении они всегда находятся в воздухе и легко попадают в организм при дыхании. Они являются сильным аллергеном и человек подвергает себя опасности заболеть хроническим насморком, кашлем и конъюнктивитом. Ухудшается общее состояние человека.
Если иммунитет оказывается слишком слаб, чтобы противостоять инфекции, то поражаются жизненно важные органы: легкие, пищевод, желудок и печень. Дальнейшее развитие нарушений приводит к серьезным болезням начиная от ринита, фарингита, бронхита и доходя до воспаления легких, отека мозга, поражений нервной системы и возникновения раковых клеток. Нередко плесень является причиной возникновения бронхиальной астмы.
Попадая на кожу, волосы и ногти, грибок вызывает различные поражения тканей. При длительном взаимодействии с плесенью появляются проблемы с опорно-двигательной системой. Под угрозой оказываются и почки, и печень, и остальные важнейшие органы человеческого организма.
Где чаще всего появляется плесень в бане
Плесневые грибы хорошо прячутся и, чтобы их вовремя обнаружить, придется потрудиться. Явная плесень проявляется только тогда, когда уже колонии довольно развиты и распространяются на стены, потолок, пол бани.
Если в сауне появился неприятный устойчивый запах сырости, то следует задуматься о присутствии скрытых спор плесени. Обнаружить ее можно в скрытых труднодоступных местах:
- в стыках бревен;
- в углах;
- по краю душевых поддонов;
- в водопроводных стоках;
- на банных полках;
- в вентиляциях трубах.
Как правило, грибок появляется в местах, которые из-за сложного доступа часто остаются недостаточно вычищенными и вымытыми. Каждая растопка и посещение бани должно завершаться тщательной уборкой в помещении с применением различных моющих средств, в составе которых присутствуют противоплесневые вещества.
Источники плесени: влажные коврики, полотенца, которые после отключения обогрева бани остаются на полу или лавках. Ширмы во внутренних помещениях бани должны быть расправлены, чтобы в складках не скапливалась влага.
Если появилась плесень в бане, как от нее избавиться? Эффективных средств, действие которых направлено на борьбу с грибком, предостаточно. Некоторые из них являются разработками химической индустрии, другие передают из поколения в поколения и представляют собой народные методы борьбы с распространением различных видов грибковых колоний в помещении бани.
Способы устранения грибка
Удалить плесень можно, используя магазинные средства, народные методы и механические способы безопасной обработки деревянных поверхностей. Перед тем как избавиться от плесени в бане, нужно оценить плюсы и минусы, а также особенности воздействия разных веществ и инструментов на древесину.
К физическим методам воздействия относят обработку бревен такими инструментами:
- наждачная бумага разной зернистости;
- шпатель;
- шлифовальная машинка;
- дрель с насадкой из жесткой щетины;
- ручная стальная щетка.
Перед удалением спор выясняют степень поражения досок. Если микроорганизмы изъели древесину глубже чем на 1 см, удалить ее насадкой или щеткой не получится.
Перед обработкой пораженную область смачивают водой. После удаления зараженный материал сжигают, а не выбрасывают. Если грибки проникли внутрь дерева, придется заменять секцию бревен, досок или вагонки.
Если вам не по душе химические антисептики от грибка, можно попробовать домашние способы на основе подручных средств. Один из самых популярных – использование хлорной извести. Ее наносят на сухую поврежденную поверхность, предварительно смешав с водой. Дополнительно можно ввести в состав часть формалина.
Народные средства от плесени
Другие методы обработки поверхностей в бане и в мойке:
- Смесь на основе медного купороса – к 50 г. вещества добавляют 1 л. воды, 30 г. соли и 100 г. алюмокалиевых квасцов. Распределить раствор по бревнам и доскам можно валиком, а щели промазать кисточкой.
- Серная смесь – перед использованием закрывают все двери и окна, а в ведре или другой огнеупорной емкости поджигают серную шашку. Для обработки 1 м. куб. используют 2 г. вещества. Нельзя допускать присутствия людей в момент уборки в помещении. Через 8 часов в баню ставят ведро негашеной извести для устранения газа и влажности.
- Перекись водорода – отличное средство для избавления от плесневого грибка в помещениях с тонкими досками. Применяют 20-25% вещество, нанося его на поврежденные участки. Через 3-4 часа поверхность протирают влажной тряпкой.
- Препараты на основе “Белизны” помогут убрать свежую плесень. Их наносят на 1-2 часа, а затем смывают чистой водой.
Предлагаем ознакомиться Двери для бани и сауны: их разновидности, особенности устройства и эксплуатации
Менее распространено применение нашатыря, уксуса и чистого спирта. Но этот способ тоже эффективен. Нашатырь разводят с водой пополам, а уксус 9% и спирт берут неразбавленным. Наносить составы нужно на 3-4 часа, после чего область хорошо промывают.
Существуют универсальные препараты, которые помогают выводить плесень любого типа. Особенно эффективны они против синего, черного налета, устойчивого к народным методам воздействия:
- Хомеенпойсто (Homeenpoisto);
- Фонгифлюид (Fongifluid);
- Сенеж-Эффо;
- Олимп Стоп-Плесен;
- Dali;
- Neomid Bio.
С химическими средствами работают в защитных масках и перчатках. После применения поверхности тщательно промывают водой.
Для успешной борьбы с плесенью в бане нужно действовать последовательно:
- Обнаружить все очаги распространения плесени (на полу, бревнах, в углах, потолке, щелях). Осмотр нужно проводить тщательно, замечая малейшие черные точки.
- Очистить видимый слой плесени шпателем и пройтись металлическойщеткой. Можно даже снять немного верхнего слоя древесины.
- Если остались следы, значит, грибок проник глубоко в дерево и следует подумать о замене пораженного участка доски. Бревно конечно заменить невозможно. Почерневшие доски пола или вагонку надо обязательно заменить на новые.
- Приступить к обработке поверхностей народными или химическими средствами. В случае глубокого поражения целесообразнее сначала убить грибок при помощи антисептиков, а потом нанести защитную пропитку.
Предотвратить появление очагов заражения плесенью на этапе, когда готовое строение введено в эксплуатацию, помогут такие мероприятия:
- Своевременный ремонт неисправных сантехнических изделий и коммуникаций.
- Проверка чистоты вентиляционных каналов и работоспособности общей системы вентиляции.
- Поддержание оптимальной температуры нагрева помещений при постоянном использовании системы отопления.
- При нечастом обогреве строения просушка всех влажных предметов обихода, для этого их выносят на открытый воздух.
- Тщательная дезинфекция и уборка после каждого использования бани, поскольку плесень часто возникает на загрязненных поверхностях. Рекомендуется применять безопасные антисептические составы для саун и бань, которые наносят на загрязненные поверхности и смывают чистой водой.
Неравный бой: грибок в бане, как избавиться
После нескольких неудачных попыток люди продолжают ломать голову над тем, как устранить грибок в бане. Действительно, зачастую состояние бывает близкое к панике: ведь не сжигать же баню напалмом, чтобы отскрести плесень?
Поспешим вас успокоить, в настоящее время химическая промышленность предлагает массу эффективных средств, но если вы сторонники антисептиков близких натуральным, то здесь вас выручат советы бывалых.
Проверенные средства: чем вывести грибок в бане
Бактерии со спорами имеют свойства не только расти вширь, но и вглубь, проникая между бревнами. Противостояние усложняется еще и тем фактором, что плесень бывает сразу не видна на поверхности, поэтому обрабатывать нужно не только зараженые очаги, а все пространство.
Стоит принять во внимание, то что средства от грибка на дереве в бане как химического происхождения, так и натурального могут воздействовать не только на злостных вредителей, но и на самого человека
Запомните, не стоит пренебрегать следующими мерами предосторожности:
Запомните, не стоит пренебрегать следующими мерами предосторожности:
- Перед началом обработки наденьте одежду из плотной ткани, перчатки, головной убор, очки и повязку или маску, защищающую дыхательные пути. Такая экипировка никогда не бывает лишней.
- После проведенных санитарных процедур не оставляйте дверь запертой. Дайте хорошо проветрится помещению.
- Когда средство подействует и в нем не будет необходимости, тщательно вымойте все поверхности с большим количеством воды.
Перейдем непосредственно к тому, как убрать грибок в бане с дерева.
Самым распространенным оружием можно назвать специальную грунтовку против плесени. При её покупке проконсультируйтесь с продавцом и убедитесь, что вещество подходит для ваших целей. Ведь плесень может прилипнуть и к кафелю, и к металлу. Вам же нужен состав безопасный для дерева. Внимательно прочтите инструкцию на обороте, где будет указано: количество грунтовки необходимое для обработки поверхностей, а также длительность воздействия.
Моем баню от грибка: дезинфекция
Поскольку дерево – это органический, натуральный материал, он активно контактирует с микроорганизмами. Плесень может проникнуть в верхние слои досок. Поэтому лучшим решением, как вывести грибок в бане на досках, станет, конечно, механический способ. Он представляет собой шлифовку, когда поверхность полируется.
Можно также счищать наросты автоматически вращающейся щеткой с грубой щетиной. Прежде чем начинать соскребать грибок, нужно обильно смочить пораженную область водой, чтобы не было вредоносной пыли. Если ситуация настолько тяжела, что требуется именно такой метод ликвидации, лучше обратиться к мастеру, который при необходимости может вырезать испорченную деталь и заменить ее.
Но в случае своевременного обнаружения достаточно эффективны химические составы
Важно отметить, что они в большинстве случаев впитываются в стены и позднее при увеличении температуры воздуха могут выбрасывать токсичные испарения. Поэтому выбирать такой состав нужно крайне внимательно
В настоящее время существует три категории обрабатывающих веществ:
- антисептики на основе масел, они считаются органическими;
- средства на водной основе;
- комбинированный противогрибковые составы.
Появился грибок в бане, но не знаете, чем его уничтожить? Смело выбирайте водные антисептики. Из всех представленных они считаются самыми безопасными, так как легко выветриваются и не проникают в саму структуру дерева. Перед применением опять же нужно внимательно ознакомиться с указаниями на этикетках продукта.
Как правильно замыть стены от грибка
Первое и главное условие использования химических средств заключается в том, чтобы в борьбе с грибком и плесенью не отравиться и не получить ожоги самому. Даже если планируется избавиться от плесени с помощью высокоэффективных фирменных препаратов, которые позиционируются в рекламе в качестве совершенно безвредных, все равно необходимо использовать респиратор и резиновые перчатки, как на видео
Сразу стоит отказаться от использования формалина — карболовой кислоты, любых видов ядов, средств для мытья и дезинфекции сантехнических изделий. Даже если удастся избавиться от грибка, в дальнейшем всем этим придется дышать в бане.
Самой безвредной считается перекись водорода. Стандартный аптечный раствор в 3% показывает слабую эффективность, хорошо помогает 7-10% раствор, но работать с ним нужно крайне осторожно, можно получить ожоги.
В качестве специализированных препаратов для удаления грибково-плесневых налетов используют Иней, Биотол, Неомид-Био. Обычно растворы разбавляют в пропорции, указанной на этикетке, и наносят вручную двукратно в течение двух часов.
Готовый раствор наносят на стены мягкой кистью небольшими порциями. На вертикальной поверхности жидкость может быстро скатываться вниз, на пол. Поэтому, чтобы повысить насыщение древесины, увлажненную препаратом часть стены энергично затирают щеткой с жесткой щетиной. Считается, что такой способ позволяет избавиться от грибка даже на растрескавшейся поверхности намного лучше и быстрее, чем при двукратной обработке.
Перечень основных рекомендаций
- Для постройки бани старайтесь использовать лес, рубленный зимой. Осенью можно заложить фундамент, а по весне ставить баню;
- Внимательно проверяйте древесину. Обнаружите характерные признаки, даже если рядом будет здоровая, не берите. Она уже поражена и появление пятен, вопрос времени;
Предлагаем ознакомиться Отделка печи плиткой своими руками │ Как наклеить плитку на печь своими руками
Если есть возможность использовать влагомер при выборе — отлично.
- Обязательно предусмотрите «продухи» для естественной вентиляции подполья, чердака и в рёбрах каркаса;
- Правильно обустройте гидроизоляцию фундамента и несущих конструкций (тоже касается пароизоляции);
- Поставьте эффективную вытяжную вентиляцию;
- Обработайте антисептиком поверхности банного помещения;
- Утеплите промерзающие внешние стены, откосы и потолок;
- Если в окнах бани установлены стеклопакеты, вставьте вентиляционные клапаны (на проветривание).
- Оперативно ремонтируйте подтекающую сантехнику и коммуникации;
- Проверяйте чистоту вентканалов и работоспособность принудительной вентиляции;
- Если баня имеет возможность постоянного отопления, обеспечьте это в достаточной мере;
- Старайтесь не оставлять в неотапливаемой бане (например, на даче), сырые ткани (полотенца, простыни и др.), а п/э ширмы (шторки) душа, всегда расправляйте для полноценного высыхания;
Плесень безумно «любит» грязь. Поэтому, регулярно и тщательно вымывайте баню. Обычное ополаскивание водой, не совсем эффективно. В продаже есть специальные бытовые средства гигиены для бани и сауны. Например, финский моющий раствор HARVIA Sauna, Tolu и другие. Их наносят мягкой губкой и смывают тёплой водой.
Еще до строительства стоит учесть:
В качестве материала для возведения бани лучше использовать лес, срубленный зимой
В осенний период лучше ограничиться закладкой фундамента, а с приходом весны уже построить саму баню. Особое внимание уделяйте контролю качества древесины. Старайтесь не брать даже здоровую древесину, если она прорастает рядом с дефектным деревом
Можно считать, что она также заражена, и то, когда на ней возникнут пятна и она начнет портиться, лишь вопрос времени.
Лучше, если под рукой будет влагомер – он значительно упростит процесс выбора нужного дерева.
В процессе возведения бани помните:
- Подполье, чердак и ребра каркаса обязательно обустройте продухами.
- На фундамент и несущие конструкции уложите качественную паро- и влагоизоляцию.
- Продумайте и установите эффективную систему вентилирования.
- Все поверхности в банных помещениях обработайте антисептическим веществом.
- Осуществите утепление откосов, потолка и внешних стен, чтобы исключить их промерзание.
- Если в бане установлены окна со стеклопакетами, то стоит вставить клапаны для вентиляции.
Во время эксплуатации не стоит забывать о таких рекомендациях:
- Старайтесь вовремя производить ремонт поврежденной сантехники и коммуникаций.
- Вовремя чистите вентиляционные каналы, а также проверяйте функциональность принудительной вентиляции.
- Если есть возможность проводить постоянное отапливание, то это положительно скажется на бане, поскольку будет препятствовать появлению плесени, а сооружение прослужит дольше.
- Не оставляйте в неотапливаемой бане любые сырые ткани, всегда обеспечивайте им полное высыхание.
Чем опасен грибок?
Споры плесневого гриба не опасны, пока находятся в неактивном состоянии. Активизируются они за счет сырости: конденсата и застаивания влаги. Плесневый гриб образует микотоксины, провоцирующие возникновение различных заболеваний. Здоровый организм среагирует на вред плесени не сразу, но позже проблемы появятся обязательно. Для человека с ослабленным иммунитетом плесень может послужить катализатором обострения болезней.
Предлагаем ознакомиться Дымоход в бане своими руками как правильно: особенности устройства и пошаговые рекомендации по сборке на фото и видео
Споры проникают в организм по воздуху и через кожу. Являются причиной следующих недомоганий:
- аллергия;
- болезни органов дыхания (бронхиты, пневмония, астма);
- проблемы с кожей-дерматит и экзема.
Причины появления грибка в бане
Грибок в банях свидетельствует о том, что вам следует в первую очередь обратить внимание на систему вентиляции. Дело в том, что в теплом и влажном воздухе создаются оптимальные условия для того, чтобы начал развиваться микроскопический грибок
И если вы вовремя не среагируете, то в течение небольшого временного промежутка споры успеют проникнуть в стены на несколько сантиметров, после чего вывести их будет уже очень сложно.
Даже на начальном этапе это задача не из легких.
Рекомендации по борьбе с грибковыми поражениями
- Предупредить грибок поможет только качественно сделанная вентиляция бани.
Для предупреждения грибка вам необходимо позаботиться о качественной вентиляции.
- Обрабатываем не место, а все помещение.
- Проверяем вентиляцию: чистим все зазоры, устраняем повреждения.
- Пожалуй, наиболее простым средством борьбы с плесенью является применения специальной грунтовки.
- При приобретении грунтовочного состава вам следует убедиться в том, что она является не профилактической, а предназначена для устранения плесени.
- Подбирайте такие составы, которые специально предназначены для деревообработки.
- В процессе обработки следует в точности соблюдать все рекомендации, включая дозировку, технику безопасности и время обработки.
Обрабатываем поверхность грунтовкой.
- Существует множество специализированных средств для борьбы с плесенью в бане. И практически все они являются небезопасными: одни разрушают древесину, другие могут нанести вред здоровью человека. Да и цена большинства составов является довольно высокой.
Поэтому, проводя обработку древесины своими руками, многие домашние мастера используют народные средства, которые и стоят дешевле, и вреда приносят меньше.
Народные средства
Существует множество народных средств, как бороться с грибком в бане.
Рассмотри самые популярные из них:
- Сера.Инструкция по проведению работ:
- На время обработки необходимо закрыть вентиляционные отверстия и заткнуть все щели.
- В металлической или керамической посудине зажгите несколько кусков серы из расчета 200 граммов серы на 100 м3 помещения.
- При серном горении выделяется сернистый газ, убивающий все грибки. Для человеческого здоровья сера тоже небезопасна, поэтому, как только она будет подожжена, сразу же выходите из помещения и плотно закройте дверь бани.
Коробка с серой.
- Спустя 6-9 часов после начала процедуры, занесите в помещение ящик с негашеной известью. Она впитает остатки сернистого газа, а также высушит помещение. Только после этого вы сможете эксплуатировать обработанную комнату.
- В первую очередь надеваем перчатки и респиратор.
- Хлорная известь.
- Очищаем стены от плесени. Для этого может быть использован шпатель.
- В небольшом количестве воды растворяем хлорную известь.
- Полученным раствором следует обработать стены.
- Еще один вариант – развести хлорную известь с формалином. Данный способ также позволяет эффективно бороться с плесенью.
Выбирая данный метод, вам необходимо учесть следующее: хлорная известь не только эффективно убивает грибок, но может нанести вред и вашим стенам. Поэтому использовать состав следует очень аккуратно.
Хлорная известь.
- Железный купорос. Является более щадящим для древесины раствором, при этом отлично убивает плесень. Раствор готовим следующим образом: смешиваем 22 грамма железного купороса, 18 грамм поваренной соли, 44 грамма алюмокалиевых квасцов. Дозировка дана на литр воды. Используя валик, пульверизатор или кисть, обрабатываем полученным составом все поверхности.
- Существует ещё несколько рецептур, которые используют для обработки стен:
- 0,4 кг борной кислоты, 1,4 л столового уксуса, 0,9 кг буры.
- 0,5 кг медного купороса и литр уксусной кислоты.
Растворы подогреваются до температуры около 70 градусов по Цельсию, после чего их распыляют или наносят кистью на поврежденные поверхности. Даем поверхностям высохнуть, а через месяц повторяем обработку.
Специальное распылительное оборудование позволяет быстрее провести обработку поверхности.
Профилактические мероприятия и уборка
Предотвратить появление плесени можно с помощью регулярной и правильной уборки помещение. Она может быть обычной, которую желательно производить после каждого посещения парилки, либо капитальной (примерно раз в месяц).
При обычной уборке сначала очищаются горизонтальные поверхности от мусора. Важно обратить внимание на пространство под сидениями. На этом этапе обнаруживается множество уже подгнивших листьев с веника. Обойдя все темные углы помещения, можно приступить непосредственно к мытью поверхностей с помощью чистящих средств. После этого желательно протереть вагонку с помощью тряпки.
Чтобы избавиться от неприятных запахов нужно проделать специальную процедуру. В парилке открываются вентиляционные отверстия, на пол выливают холодную воду и разогревают баню до высоких температур. Вода, испаряясь, будет забирать с собой неприятные запахи и покидать помещение через вентиляцию.
Тщательно и глубоко убирать баню желательно при капитальной уборке. Здесь на помощь приходят различные пылесосы, пароочистители и т. д. Иногда владельцы бань используют химические вещества, чтобы предотвратить дальнейшее образование плесени. Древесина имеет свойство приобретать черный цвет со временем, поэтому дерево и бревна покрывают специальным раствором, не позволяющим ему чернеть.